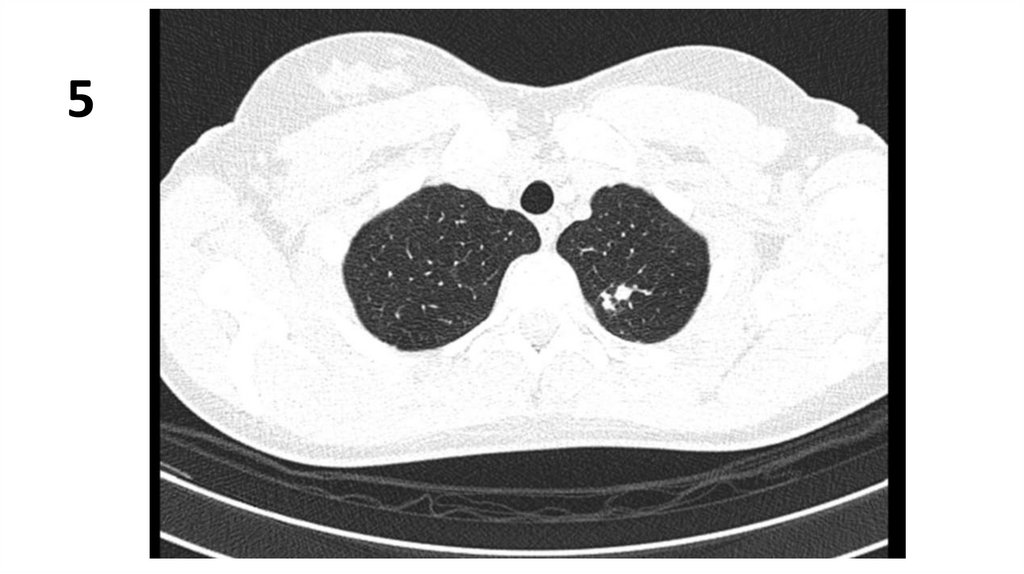

Similar presentations:
Оценка рентгенограммы
1.
Оценка рентгенограммыОписать одну рентгенограмму. Номер рентгенограммы соответствует
вашему номеру в журнальном списке группы.
Схема описания:
1. Опишите представленные снимки, выделите основной рентгенологический
синдром.
2. Имеются ли признаки туберкулеза на данных снимках? Если да,
перечислите их.
3. При наличии признаков туберкулеза определите форму, фазу процесса,
укажите возможные осложнения.
4.Составьте дифференциально-диагностический ряд, укажите наиболее
вероятные заболевания.
5. Какие методы верификации диагноза применимы в данном случае.

medicine
medicine








